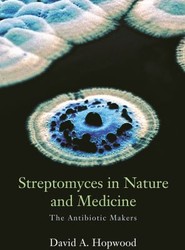
Streptomyces in Nature and Medicine

Published March, 2007
By Alan Baddeley
Publisher: Oxford University Press
Series: Oxford Psychology Series
Rating:
Availability: Available
By Alan Baddeley
Publisher: Oxford University Press
Series: Oxford Psychology Series
Rating:
Availability: Available
'Working Memory, Thought, and Action' is the magnum opus of one of the most influential cognitive psychologists of the past 50 years. This new volume on the model he created (with Grahame Hitch) discusses the developments that have occurred within the model in the past twenty years, and places it within a broader context.
Hardback
€164.70
€71.98
Published March, 2007
By Norman Sartorius, Aleksandar Janca, Kim Hopper and Glynn Harrison
Publisher: Oxford University Press (Oxford University Press Inc)
Rating:
Availability: Available
By Norman Sartorius, Aleksandar Janca, Kim Hopper and Glynn Harrison
Publisher: Oxford University Press (Oxford University Press Inc)
Rating:
Availability: Available
Hardback
€98.82
Published March, 2007
By Penney Lewis
Publisher: Oxford University Press
Rating:
Availability: Available
By Penney Lewis
Publisher: Oxford University Press
Rating:
Availability: Available
The question of whether euthanasia and assisted suicide should be legalized is often treated as a universal, ethical question, transcending national boundaries and diverse legal systems. This book examines the impact of the choice of diverse legal routes towards legalization on the subsequent assisted dying regimes in operation.
Hardback
€155.55
Published March, 2007
By Barry Halliwell, John Gutteridge, John M. C. Gutteridge, Halliwell and Gutteridge
Publisher: Oxford University Press
Rating:
Availability: Contact supplier
By Barry Halliwell, John Gutteridge, John M. C. Gutteridge, Halliwell and Gutteridge
Publisher: Oxford University Press
Rating:
Availability: Contact supplier
Provides coverage of isoprostanes and related compounds, mechanisms of oxidative damage to DNA and proteins (and the repair of such damage), the free radical theory of ageing and the roles played by reactive species in signal transduction, cell death, human reproduction, and other important biological events.
Hardback
€108.58
Published March, 2007
By Richard A. Rettig, Peter D. Jacobson, Cynthia M. Farquhar, Wade M. Aubry and Cynthia Farquhar
Publisher: Oxford University Press (Oxford University Press Inc)
Rating:
Availability: Available
By Richard A. Rettig, Peter D. Jacobson, Cynthia M. Farquhar, Wade M. Aubry and Cynthia Farquhar
Publisher: Oxford University Press (Oxford University Press Inc)
Rating:
Availability: Available
In the late 1980s, a promising new treatment for breast cancer emerged: high-dose chemotherapy with autologous bone marrow transplantation or HDC/ABMT. This book tells of the rise and demise of HDC/ABMT for metastatic and early stage breast cancer, and explores the story's implications, and how we evaluate other medical procedures.
Hardback
€51.84
Published March, 2007
By Perry A. Frey and Adrian D. Hegeman
Publisher: Oxford University Press (Oxford University Press Inc)
Rating:
Availability: Available
By Perry A. Frey and Adrian D. Hegeman
Publisher: Oxford University Press (Oxford University Press Inc)
Rating:
Availability: Available
Intended for students, medicinal chemists and biotechnologists, this title deals with mechanisms of enzymatic reactions.
Hardback
€301.95
Published February, 2007
By David A. Hopwood
Publisher: Oxford University Press (Oxford University Press Inc)
Rating:
Availability: Available
By David A. Hopwood
Publisher: Oxford University Press (Oxford University Press Inc)
Rating:
Availability: Available
This book highlights the lives of a group of soil microbes that make most of the antibiotics used in medicine today. Written by an insider, it describes how genetics tells us how these microscopic chemists compete in the soil and how their genes can be rearranged to make new antibiotics to fight re-emerging diseases.
Hardback
€71.98
Published February, 2007
By Bee Wee, Nic Hughes and Nick Hughes
Publisher: Oxford University Press
Rating:
Availability: Available
By Bee Wee, Nic Hughes and Nick Hughes
Publisher: Oxford University Press
Rating:
Availability: Available
Education is key to developing a strong base for the future of palliative care, and this book provides a wide-ranging, global view of palliative care education. It offers theoretical and practical insights, along with specific suggestions for developing knowledge and skills for teaching.
Paperback / softback
€82.96
Published February, 2007
By Elizabeth A. Martin
Publisher: Oxford University Press
Rating:
Availability: Contact supplier
By Elizabeth A. Martin
Publisher: Oxford University Press
Rating:
Availability: Contact supplier
Serving as a reference for both medical students and those working in the medical and allied professions, this dictionary contains over 11,000 entries, covering various aspects of medical science. These entries are complemented by over 140 illustrations and diagrams.
Spiral bound
€15.85
Published February, 2007
By Bonnie Steinbock
Publisher: Oxford University Press
Series: Oxford Handbooks
Rating:
Availability: Available
By Bonnie Steinbock
Publisher: Oxford University Press
Series: Oxford Handbooks
Rating:
Availability: Available
Bonnie Steinbock presents the authoritative, state-of-the-art guide to current issues in bioethics, covering 30 topics in original essays by some of the world's leading figures in the field, as well as by some newer 'up-and-comers'. Anyone who wants to know how the central debates in bioethics have developed in recent years, and where the debates are going, will want to consult this book.
Hardback
€152.50
€54.28